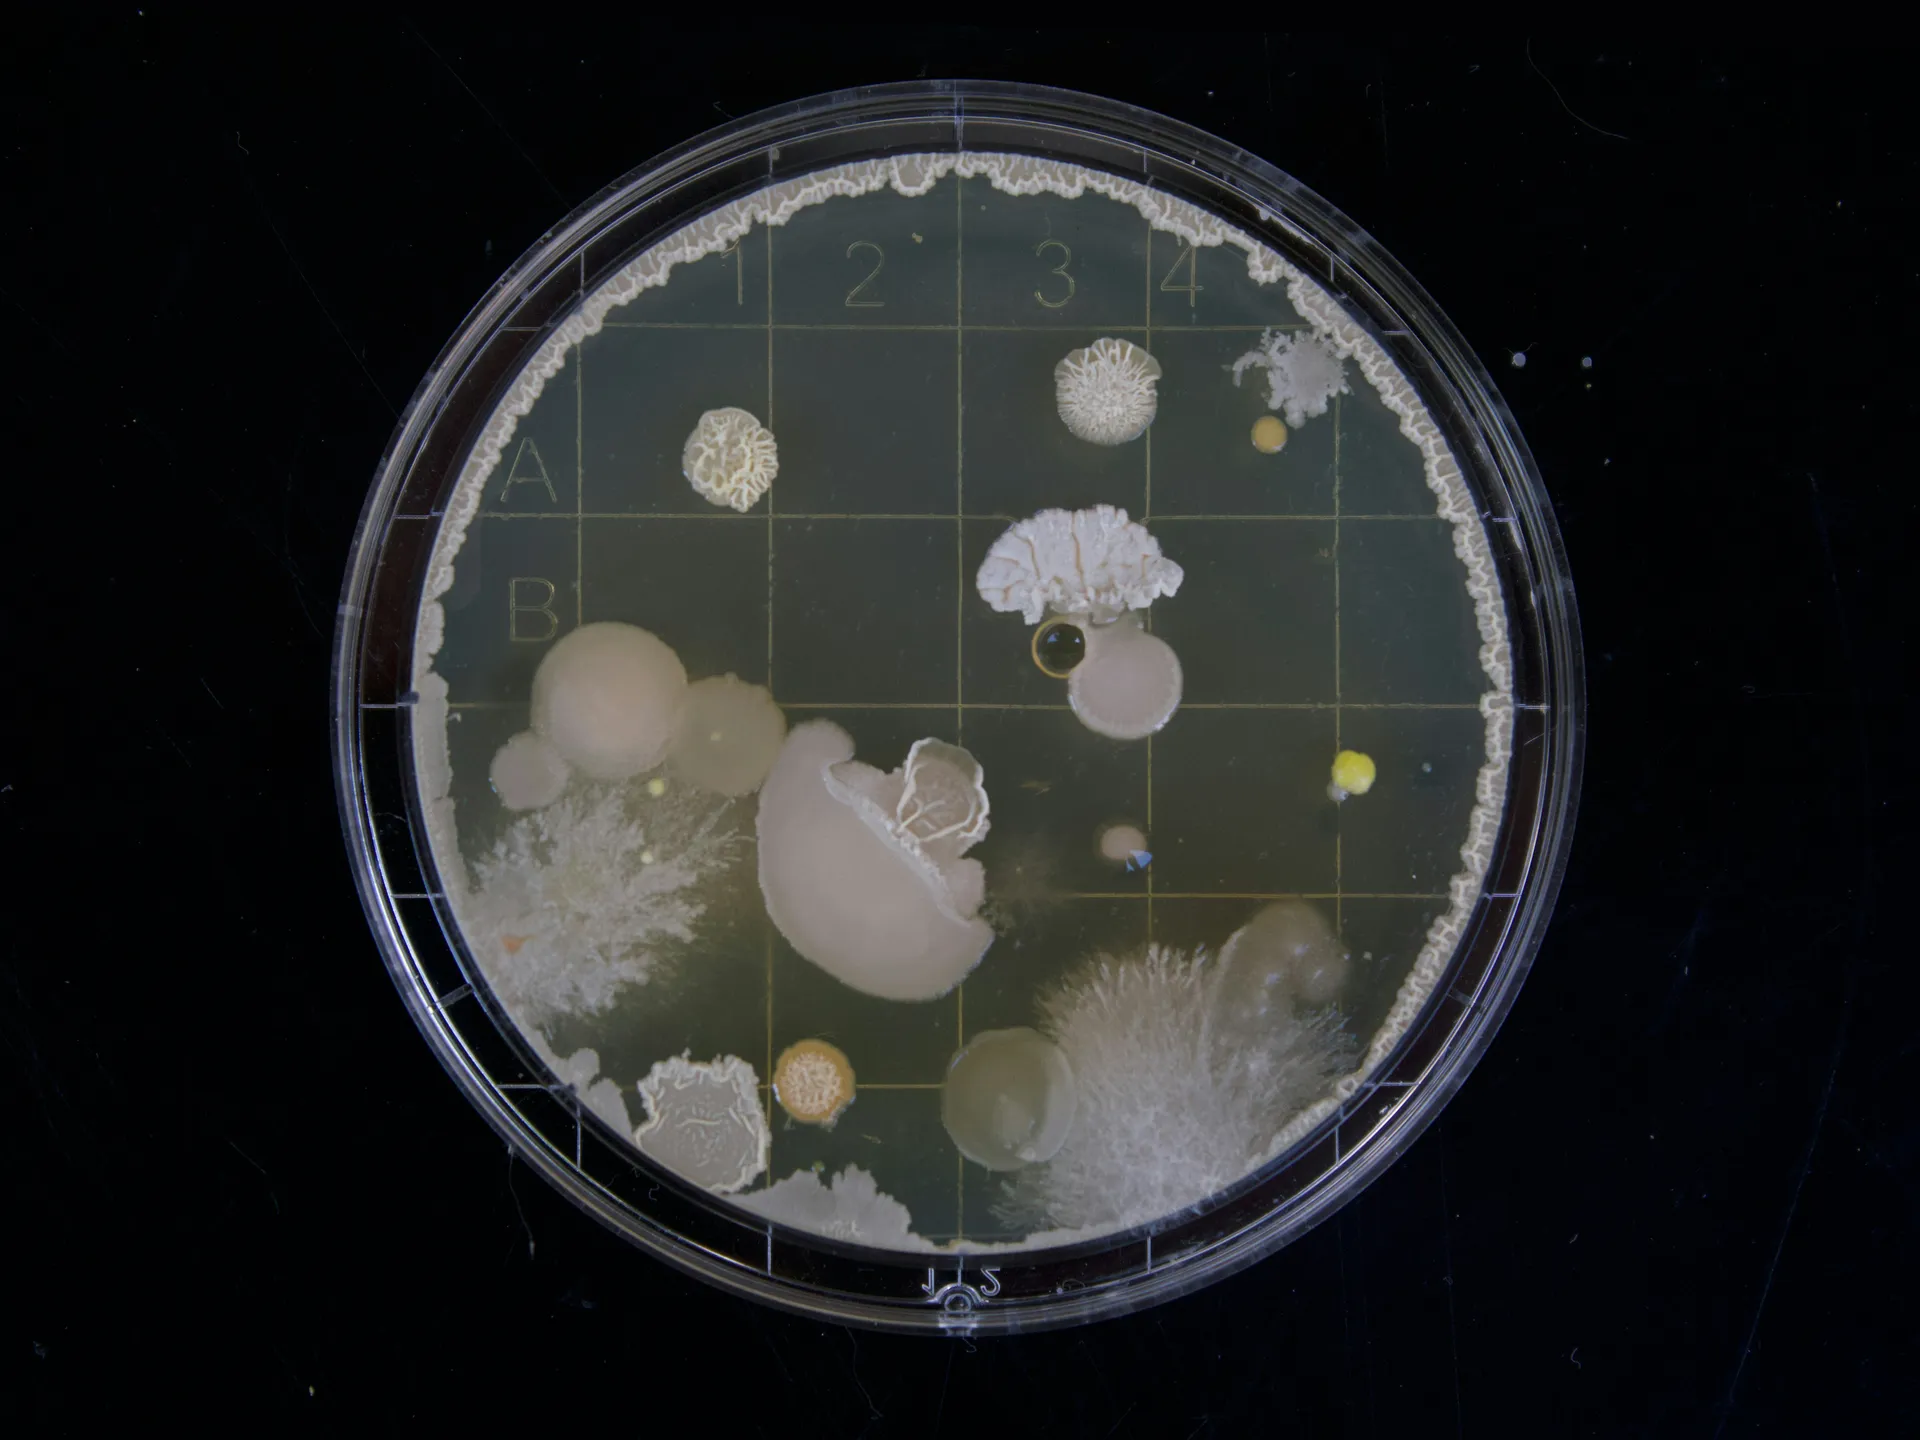
Baktériumtenyészet petri csészén

Technológia
A mesterséges intelligencia és az IoT-érzékelők együtt képes megjósolni a csőtöréseket, optimalizálni a hálózati nyomást és valós időben csökkenteni az elosztási veszteséget.
Egy kazahsztáni kutatás bemutatja, hogyan tanulhat meg gondolkodni egy szennyvíztelep IoT-érzékelők, hidraulikai szimuláció és mesterséges intelligencia segítségével.
Ausztrál kutatók egy újrafelhasználható, nano-méretű molekuláris kalitkákból álló abszorbenst fejlesztettek ki, amely akár 98%-os hatékonysággal távolítja el a PFAS-szennyezőket a vízből – beleértve a legnehezebben kezelhető rövid láncú változatokat is.
Új kutatási eredmények szerint 500 °C felett az aktív szén felülete katalizátorként segíti a PFAS-vegyületek lebomlását – de a folyamat környezeti ára sem elhanyagolható.
Három "ökobarát" innovációt kínálnak kutatók, amelyek elterjedésük esetén jelentősen javíthatják az energiatermelés és a szennyvíztisztítás hatékonyságát.
Forradalmi kísérlet a mikroműanyagok tisztított szennyvízből történő eltávolítása érdekében
Brit kutatók egy mesterséges intelligenciával támogatott döntéstámogató rendszert fejlesztettek, amely szabályozói jelentésekből tanul, és valós idejű segítséget nyújt vízminőségi incidensek kezelésekor.
Egy nemzetközi kutatócsoport szerint a mikrobiális elektrokémiai technológiák képesek lehetnek arra, hogy a szennyvízkezelést önfenntartó erőforrás-visszanyerési rendszerré alakítsák.
Egy indiai kutatócsoport fotokatalitikus nanoreaktort fejlesztett, amely vegyszerek nélkül bontja le a szennyvíz legmakacsabb mikroszennyezőit.
1
...